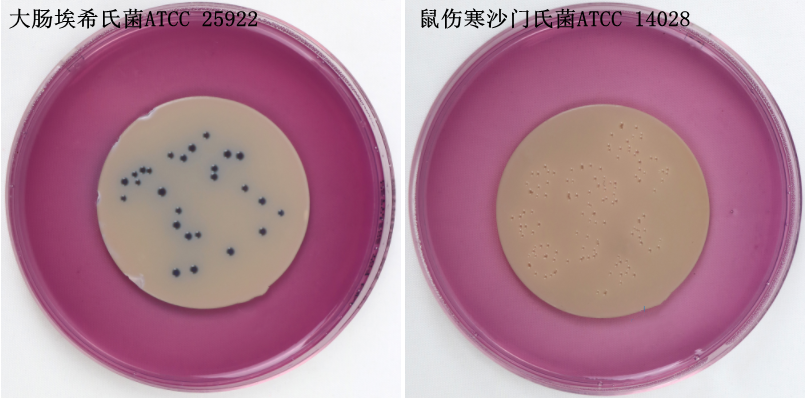

海博微信公众号
海博微信公众号
 海博天猫旗舰店
海博天猫旗舰店


 海博微信公众号
海博微信公众号
 海博天猫旗舰店
海博天猫旗舰店




一、粪大肠菌群情况简要介绍
粪大肠菌群,又称耐热大肠菌群(thermotolerant coliforms),44.5℃培养24h,能在MFC选择性培养基上生长,发酵乳糖产酸,并形成蓝色或蓝绿色菌落的肠杆菌科细菌。
该菌群来自人和温血动物粪便,作为粪便污染指标评价食品的卫生状况,推断食品中肠道致病菌污染的可能性。
二、参考标准
《HJ347.1-2018水质粪大肠菌群的测定滤膜法》点击下载
三、检验原理
样品通过孔径为0.45μm的滤膜过滤,细菌被截留在滤膜上,然后将滤膜置于MFC选择性培养基上,在特定的温度(44.5℃)下培养24h,胆盐三号可抑制革兰氏阳性菌的生长,粪大肠菌群能生长并发酵乳糖产酸使指示剂变色,通过颜色判断是否产酸,并通过呈蓝色或蓝绿色菌落计数,测定样品中粪大肠菌群浓度。
四、检验方法以及结果分析
4.1 样品
4.1.1 样品采集
点位布设及采样频次按照GB/T14581、HJ/T494和HJ/T91的相关规定执行。采集微生物样品时,采样瓶不得用样品洗涤,采集样品于灭菌的采样瓶中。样品采集量可根据水体实际情况而定,一般不少于250mL。
采集河流、湖库等地表水样品时,可握住瓶子下部直接将带塞采样瓶插入水中,约距水面10cm~15cm处,瓶口朝水流方向,拔瓶塞,使样品灌入瓶内然后盖上瓶塞,将采样瓶从水中取出。如果没有水流,可握住瓶子水平往前推。采样量一般为采样瓶容量的80%左右。样品采集完毕后,迅速扎上无菌包装纸。
从龙头装置采集样品时,不要选用漏水龙头,采水前将龙头打开至最大,放水3min~5min,然后将龙头关闭,用火焰灼烧约3min灭菌或用70%~75%的酒精对龙头进行消毒,开足龙头,再放水1min,以充分除去水管中的滞留杂质。采样时控制水流速度,小心接入瓶内。
采集地表水、废水样品及一定深度的样品时,也可使用灭菌过的专用采样装置采样。在同一采样点进行分层采样时,应自上而下进行,以免不同层次的搅扰。
如果采集的是含有活性氯样品,需在采样瓶灭菌前加入硫代硫酸钠溶液,以除去活性氯对细菌的抑制作用(每125mL容积加入0.1mL的硫代硫酸钠溶液);如果采集的是重金属离子含量较高的样品,则在采样瓶灭菌前加入乙二胺四乙酸二钠溶液,以消除干扰(每125mL容积加入0.3mL的乙二胺四乙酸二钠溶液)。
注:15.7mg硫代硫酸钠可去除样品中1.5mg活性氯,硫代硫酸钠用量可根据样品实际活性氯量调整。
4.1.2 样品保存
采样后应在2h内检测,否则,应10℃以下冷藏但不得超过6h。实验室接样后,不能立即开展检测的,将样品在4℃以下冷藏并在2 h内检测。
4.2 分析步骤
4.2.1 样品过滤
根据样品的种类判断接种量,最小过滤体积为10mL,如接种量小于10mL时应逐级稀释。
先估计出适合在滤膜上计数所使用的体积,然后再取这个体积的1/10和10倍,分别过滤。理想的样品接种量是滤膜上生长的粪大肠菌群菌落数为20个~60个,总菌落数不得超过200个。当最小过滤体积为10mL,滤膜上菌落密度仍过大时,则应对样品进行稀释。1:10稀释的方法为:吸取10mL样品,注入盛有90mL无菌水的三角烧瓶中,混匀,制成1:10稀释样品。样品接种量参考表见表1。
表1 接种量参考表

用灭菌镊子以无菌操作夹取无菌滤膜贴放在已灭菌的过滤装置上,固定好过滤装置,将样品充分混匀后抽滤,以无菌水冲洗器壁2次~3次。样品过滤完成后,再抽气约5s,关上开关。
4.2.2 培养
用灭菌镊子夹取滤膜移放在MFC培养基上,滤膜截留细菌面向上,滤膜应与培养基完全贴紧,两者间不得留有气泡,然后将培养皿倒置,放入恒温培养箱内,44.5℃±0.5℃培养24h±2h。
MFC培养基检验原理:胰胨、多胨和酵母膏粉提供氮源、维生素和生长因子;氯化钠维持均衡的渗透压;乳糖为可发酵糖类;三号胆盐抑制革兰氏阳性菌;琼脂是培养基的凝固剂;玫红酸和苯胺蓝为pH指示剂。粪大肠菌群可在44.5℃条件下分解乳糖产酸,使培养基pH下降,菌落为亮蓝色,其他不发酵乳糖的肠道菌菌落为无色、灰色或淡红色。
用法:称取本品52.3克,加热煮沸溶解于1000mL蒸馏水中,冷却至45℃-50℃时,倾入无菌平皿。无需高压灭菌。
图1 不同细菌在MFC琼脂上的生长特征
4.2.3 对照试验
(1)空白对照
每次试验都要用无菌水按照步骤4.2.1和4.2.2进行实验室空白测定。
(2)阳性及阴性对照
将粪大肠菌群的阳性菌株(如大肠埃希氏菌Escherichia coli)和阴性菌株(如产气肠杆菌Enterobacter aerogenes)制成浓度为40~600CFU/L的菌悬液,分别按照4.2.1~4.2.2步骤培养,阳性菌株应呈现阳性反应,阴性菌株应呈现阴性反应,否则,该次样品测定结果无效,应查明原因后重新测定。
五、结果计算与表示
5.1 结果判读
MFC培养基上呈蓝色或蓝绿色的菌落为粪大肠菌群菌落,予以计数。MFC培养基上呈灰色、淡黄色或无色的菌落为非粪大肠菌群菌落,不予计数。
5.2 结果计算
样品中的粪大肠菌群数(CFU/L),按照下列公式进行计算:

式中:C——样品中粪大肠菌群数,CFU/L;
C1——滤膜上生长的粪大肠菌群菌落总数,个;
1000——将过滤体积的单位由mL转换为L;
f——样品接种量,mL;
注:若平行样结果都在20~60CFU/L范围内,最终结果取平均值以几何平均计算。
5.3 结果表示
测定结果保留至整数位,最多保留两位有效数字,当测定结果≥100 CFU/L时,以科学计数法表示。
六、注意事项:
6.1 活性氯具有氧化性,能破坏微生物细胞内的酶活性,导致细胞死亡,可在样品采集时加硫代硫酸钠溶液消除干扰。
6.2 重金属离子具有细胞毒性,能破坏微生物细胞内的酶活性,导致细胞死亡,可在样品采集时加入乙二胺四乙酸二钠溶液消除干扰。
相关产品:
相关标准:
HJ 347.1-2018 水质 粪大肠菌群的测定 滤膜法 点击下载
注:本文属海博生物原创,未经允许不得转载。
上一篇:GB4789.40-2016 克罗诺杆菌属(阪崎肠杆菌)检验方法及结果分析
下一篇:空肠弯曲菌检验方法及结果判断



